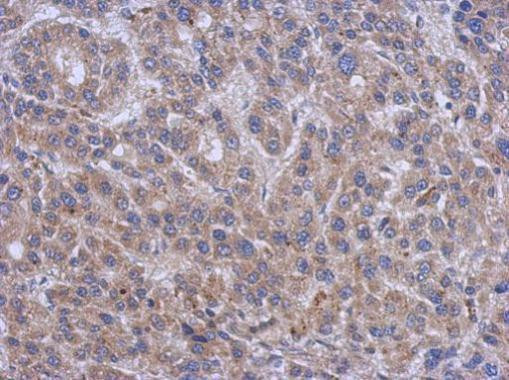
SPTLC2 Antibody in Immunohistochemistry (Paraffin) (IHC (P))

Search
Invitrogen
SPTLC2 Polyclonal Antibody
{{$productOrderCtrl.translations['antibody.pdp.commerceCard.promotion.promotions']}}
{{$productOrderCtrl.translations['antibody.pdp.commerceCard.promotion.viewpromo']}}
{{$productOrderCtrl.translations['antibody.pdp.commerceCard.promotion.promocode']}}: {{promo.promoCode}} {{promo.promoTitle}} {{promo.promoDescription}}. {{$productOrderCtrl.translations['antibody.pdp.commerceCard.promotion.learnmore']}}
产品信息
PA5-31130
种属反应
宿主/亚型
分类
类型
抗原
偶联物
形式
浓度
规格
纯化类型
保存液
内含物
保存条件
运输条件
RRID
产品详细信息
Recommended positive controls: NT2D1, IMR32, U87-MG, MCF-7, mouse liver.
Predicted reactivity: Mouse (95%), Rat (95%), Xenopus laevis (80%), Chicken (84%), Bovine (95%).
Store product as a concentrated solution. Centrifuge briefly prior to opening the vial.
靶标信息
Serine palmitoyltransferase (SPT), which consists of two different subunits, is the key enzyme in sphingolipid biosynthesis. It converts L-serine and palmitoyl-CoA to 3-oxosphinganine with pyridoxal 5'-phosphate as a cofactor. SPT2 is the long chain base subunit 2 of mammalian serine palmitoyltransferase. SPT2 is catalytically active but needs its related protein SPT1 for its stabilization and anchoring the holoenzyme to the cytosolic face of the endoplasmic reticulum. As in the case with SPT1, mutations in the SPT2 gene can cause hereditary sensory and autonomic neuropathy type I (HSAN-I), resulting from a loss of SPT activity as well as the accumulation of the atypical and neurotoxic sphingoid metabolite 1-deoxy-sphinganine.
⚠WARNING: This product can expose you to chemicals including mercury, which is known to the State of California to cause birth defects or other reproductive harm. For more information go to www.P65Warnings.ca.gov.
仅用于科研。不用于诊断过程。未经明确授权不得转售。
篇参考文献 (0)
生物信息学
蛋白别名: LCB 2; LCB2a; Long chain base biosynthesis protein 2; Long chain base biosynthesis protein 2a; Serine palmitoyltransferase 2; serine palmitoyltransferase, subunit II; Serine-palmitoyl-CoA transferase 2; SPT 2
基因别名: AI173915; hLCB2a; HSN1C; KIAA0526; LCB2; LCB2A; mKIAA0526; NSAN1C; SPT2; SPTLC2
UniProt ID: (Human) O15270, (Mouse) P97363
Entrez Gene ID: (Human) 9517, (Mouse) 20773